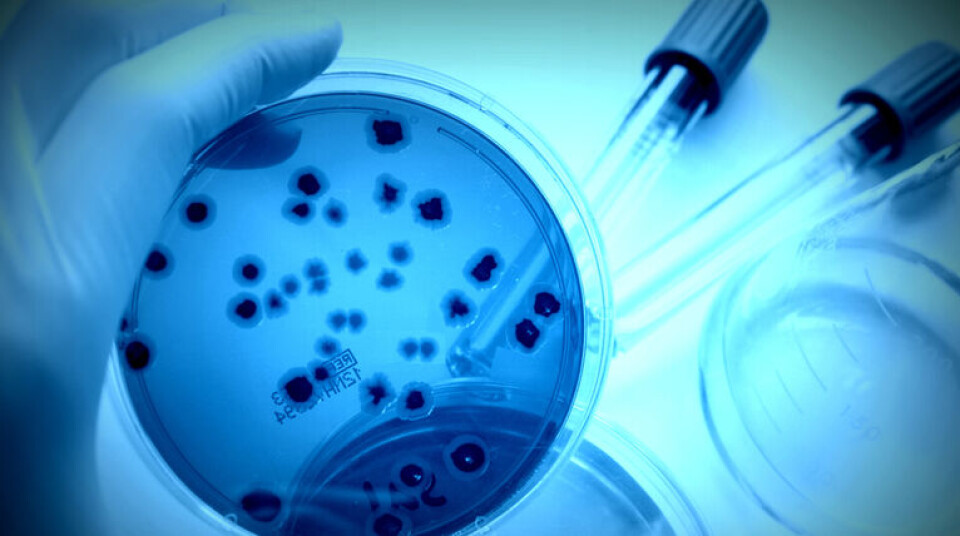
INFEKSJONSFARE: Mer resistente bakterier gjør det vanskeligere å behandle alvorlige matbårne infeksjoner. (Foto: Shutterstock)

Annonse
bakterier
Flere resistente bakterier
Resistente salmonella- og campylobacter-bakterier sprer seg i Europa.
Annonse
Det er en rapport fra den EUs trygg mat-byrå Efsa og det europeiske smitteverninstituttet ECDC som viser at forekomsten av antibiotikaresistente salmonella- og campylobacter-bakterier hos mennesker og dyr øker i Europa.Rapporten viser at multiresistente salmonella-bakterier fortsetter å spre seg i Europa. Forskere advarer også mot campylobacter-bakterier som ofte er motstandsdyktige mot ciprofloksacin, som er viktig for å behandle infeksjoner hos mennesker. Resistensen gjør det vanskeligere å behandle alvorlige matbårne infeksjoner.Ifølge rapporten er det også påvist resistens mot colistin i salmonella og E. coli hos fjærfe i EU.Først og fremst er det i Øst- og Sør-Europa de antibiotikaresistente bakteriene finnes, melder Vitenskapskomiteen for mattrygghet.